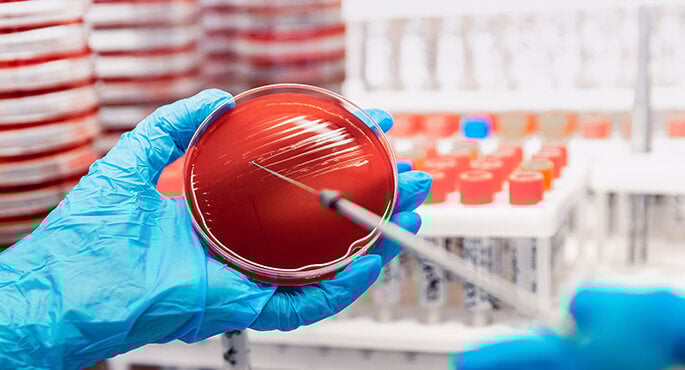
Hände in Laborhandschuhen halten eine Agarplatte und Pipette. Im Hintergrund sind weitere Agarplatten und Probenröhrchen zu sehen.

Mit großem Temperaturbereich
Serie KB
Produkte anzeigen
Ein Kühlinkubator, auch Kühlbrutschrank genannt, ist ein Inkubator, der nicht nur heizen, sondern auch kühlen kann. Durch dieses Temperiersystem können Proben in einem Kühlinkubator sowohl oberhalb als auch unterhalb der Umgebungstemperatur inkubiert oder gelagert werden. Kühlbrutschränke kommen in der Mikrobiologie zum Einsatz und gehören dort zur Standard-Laborausstattung. Stabile Inkubationsbedingungen sind bei der Arbeit mit Mikroorganismen unerlässlich. Die dafür verwendeten Geräte müssen deshalb exakte und konstante Temperaturen garantieren.

Ein Kühlinkubator verfügt über einen Innenraum (Nutzraum), in dem die gewünschte Temperatur eingeregelt und aufrechterhalten wird.
Die besonders gleichmäßige Temperatur über alle Einschübe hinweg wird in Kühlbrutschränken von BINDER durch die doppelseitige horizontale Luftführung erreicht. Die Luft wird durch einen Ventilator nach hinten in die doppelte Rückwand gesaugt. Im hinteren Bereich des Brutschrankes, der nicht zum Nutzraum gehört, wird die Luft rekonditioniert und somit auf die eingestellte Temperatur angepasst, bevor sie zu beiden Seiten durch die perforierten Seitenwände wieder in den Nutzraum des Gerätes geführt wird. Durch diesen doppelseitigen horizontalen Luftstrom werden homogene und stabile Temperaturen in den Geräten von BINDER erreicht. Eine Glasinnentür ermöglicht die Sicht auf die Proben, ohne dass dabei die Atmosphäre im Innenraum beeinflusst wird.
Kühlinkubatoren finden in der Mikrobiologie in verschiedenen Branchen und Bereichen Verwendung, zum Beispiel in der pharmazeutischen und medizinischen Forschung, in der Lebensmittelindustrie oder bei der Umweltüberwachung. Weitere Anwendungsgebiete sind die Batterieforschung und -entwicklung, bei denen Kühlinkubatoren als „Klimaschränke ohne Feuchteregelung“ zum Einsatz kommen.

Die Richtlinien der Guten Laborpraxis (GLP) und der Guten Herstellungspraxis (GMP) regeln die Anwendungen, die mit Kühlinkubatoren durchgeführt werden.
In der pharmazeutischen Industrie sind die Anforderungen der Guten Laborpraxis (GLP) und der Guten Herstellungspraxis (GMP) in der FDA-Richtlinie 21 CFR Teil 11 beschrieben, sie regelt die Handhabung der Messvorrichtungen, die in definierten Abständen kalibriert und geprüft werden müssen.
Alles Wissenswerte zur GLP finden Sie in unserem Whitepaper: „Die Gute Laborpraxis: Was steckt dahinter?“
Inbetriebnahme und Qualifizierung der Kühlinkubatoren von BINDER:
Insgesamt durchläuft der Kühlbrutschrank bei der Validierung drei Schritte:
Es gibt kompressorbasierte Kühlbrutschränke, die mit Kältemittel arbeiten und Peltier-basierte Geräte, die thermoelektrisch heizen und kühlen. Jede der beiden Technologien erfüllt andere Anforderungen und ist damit für andere Anwendungen geeignet. Geräte mit Peltier-Technologie sind umweltfreundlicher und leiser und verbrauchen deutlich weniger Energie als Modelle mit Kompressor. Für Anwendungen deutlich unterhalb der Umgebungstemperatur oder mit Wärmeeintrag sind Kompressorgeräte die bessere Wahl. Welche Technik am besten passt, hängt immer von den Bedürfnissen des Anwenders ab und davon, welche Anwendungen durchgeführt werden sollen.
Die Luftbewegung ist ausschlaggebend für die gleichmäßige Temperaturverteilung im Inneren des Inkubators. Eine besonders homogene Verteilung wird bei Geräten von BINDER mit der doppelseitigen horizontalen Luftführung erreicht. Hierbei wird die Luft mit einem Ventilator in die doppelte Rückwand abgesaugt und nach erneuter Konditionierung wieder in den Nutzraum zurückgeführt. Über kleine Perforationen in den Seitenwänden wird die Luft gleichmäßig im Nutzraum verteilt und strömt so von beiden Seiten gleichmäßig über das Testgut.
Bei Kühlbrutschränken von BINDER kann die Temperatur so programmiert werden, dass sie zu festgelegten Zeiten auf Kühlschrankbedingungen, zum Beispiel 4°C, heruntergefahren wird. Damit fungiert der Brutschrank als „Wochenendkühlschrank“, das Umlagern der Proben in einen separaten Kühlschrank entfällt.
Abhängig von der Beladung, zum Beispiel mit einer großen Anzahl an Agarplatten, kann viel Feuchtigkeit im Inneren der Kammer entstehen, was schließlich zu Kondensation führen kann. Um in solchen Fällen ein optimales Kulturwachstum zu gewährleisten, verfügen Geräte von BINDER über die Funktion „Betauungsschutz“, die überschüssige Feuchtigkeit außerhalb des Probenraums beseitigt. Diese Funktion kann über den Regler mit einer Intensität von 0 bis 100 Prozent eingestellt werden. Für die meisten Anwendungen ist eine Intensität von 40 Prozent geeignet.
Kühlinkubatoren von BINDER sind so konzipiert, dass sie besonders dicht sind und der Innenraum vollständig von der Außenumgebung getrennt ist, wodurch die Temperatur im Inneren stabil bleibt. Dadurch werden Proben, beispielsweise Agarplatten, auch bei längerer Inkubationsdauer vor dem Austrocknen geschützt. Bei kleinen Probenmengen empfiehlt sich gleichzeitig das Einstellen des Betauungsschutzes auf einen niedrigen Wert.
BINDER bietet ein umfangreiches Sortiment an Kühlbrutschränken an. Die Geräte sind in sieben verschiedenen Größen und mit unterschiedlichen Temperaturbereichen erhältlich. Vor dem Kauf sollte genau analysiert werden, für welche Anwendung das Gerät benötigt wird. In jedem Fall sollte ein Kühlinkubator präzise und homogene Temperaturen und einen ausfallsicheren Langzeitbetrieb garantieren.
Die doppelseitige horizontale Luftführung sorgt bei allen BINDER Kühlinkubatoren für eine gleichmäßige Temperaturverteilung – auch bei voller Beladung des Schrankes.
Die Serie KB mit einem Temperaturbereich von 0 °C bis +70 °C inkubiert selbst in voll beladenem Zustand präzise und ist optimal geeignet für die Inkubation von Mikroorganismen. Sie beherrscht eine Heißluft-Desinfektionsroutine bei 100 °C und lässt sich als “Wochenendkühlschrank” programmieren.
Mit einem Temperaturbereich von -20°C bis +100 °C ist die Serie KB PRO unsere leistungsstärkste Serie von Kühlinkubatoren. Sie verfügt über umfangreiche Programmfunktionen und deckt ein breites Anwendungsspektrum ab. Mit den zusätzlich erhältlichen Lichtmodulen eignen sich die Geräte für ICH-Photostabilitätstests oder als Pflanzenwuchsschrank. Wieviel Energie sich mit der KB PRO-Serie einsparen lässt, können Sie mit dem Energiesparrechner ganz einfach ausrechnen.
Umweltfreundlich und energiesparend sind die Peltier-basierten Serien KT, mit einem Temperaturbereich von +4 °C bis +100 ° C, und KB ECO mit einem Temperaturbereich von 0°C bis +70 °C. Dank thermoelektrischer Kühlung arbeiten die Geräte klimaneutral ohne Kältemittel. Standgeräte der Serie KB ECO sind zudem durch die patentierte Wärmeabführung besonders energieeffizient.